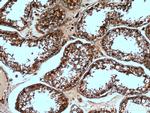
ASS1 Antibody in Immunohistochemistry (Paraffin) (IHC (P))

Search
Proteintech
ASS1 Polyclonal Antibody
{{$productOrderCtrl.translations['antibody.pdp.commerceCard.promotion.promotions']}}
{{$productOrderCtrl.translations['antibody.pdp.commerceCard.promotion.viewpromo']}}
{{$productOrderCtrl.translations['antibody.pdp.commerceCard.promotion.promocode']}}: {{promo.promoCode}} {{promo.promoTitle}} {{promo.promoDescription}}. {{$productOrderCtrl.translations['antibody.pdp.commerceCard.promotion.learnmore']}}
产品信息
16210-1-AP
种属反应
已发表种属
宿主/亚型
分类
类型
抗原
偶联物
形式
浓度
规格
纯化类型
保存液
内含物
保存条件
运输条件
产品详细信息
Immunogen sequence: EFYNRFKGR NDLMEYAKQH GIPIPVTPKN PWSMDENLMH ISYEAGILEN PKNQAPPGLY TKTQDPAKAP NTPDILEIEF KKGVPVKVTN VKDGTTHQTS LELFMYLNEV AGKHGVGRID IVENRFIGMK SRGIYETPAG TILYHAHLDI EAFTMDREVR KIKQGLGLKF AELVYTGFWH SPECEFVRHC IAKSQERVEG KVQVSVLKGQ VYILGRESPL SLYNEELVSM NVQGDYEPTD ATGFININSL RLKEYHRLQS KVTAK (149-412 aa encoded by BC009243)
靶标信息
The protein encoded by this gene catalyzes the penultimate step of the arginine biosynthetic pathway. There are approximately 10 to 14 copies of this gene including the pseudogenes scattered across the human genome, among which the one located on chromosome 9 appears to be the only functional gene for argininosuccinate synthetase. Mutations in the chromosome 9 copy of ASS cause citrullinemia. Two transcript variants encoding the same protein have been found for this gene.
仅用于科研。不用于诊断过程。未经明确授权不得转售。
生物信息学
蛋白别名: Argininosuccinate synthase; argininosuccinate synthetase; argininosuccinate synthetase 1; arginosuccinate synthetase 1; Citrulline--aspartate ligase; citrulline-aspartate ligase; epididymis secretory sperm binding protein; RP11-618A20.2; unnamed protein product
基因别名: AA408052; ASS; Ass-1; ASS1; ASSA; CTLN1; fold
UniProt ID: (Human) P00966, (Rat) P09034, (Mouse) P16460
Entrez Gene ID: (Human) 445, (Rat) 25698, (Mouse) 11898